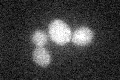
YLR326W
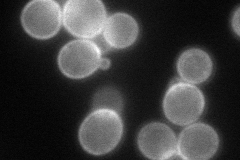
YLR326W
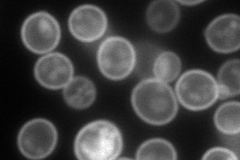
YLR326W
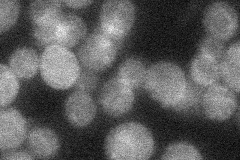
YLR326W
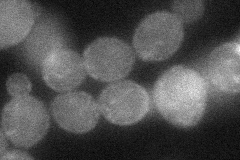
YLR326W
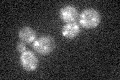
YLR326W
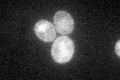
YLR326W

View description
Putative protein of unknown function, predicted to be palmitoylated
Localization:
Intensity:
Fold change:
Significance:
-
C’ GFP library in SD
cytosol23.95 -
N' NOP1pr-GFP in SD
cell periphery95.181 -
N' TEF2pr-mCherry in SD
cell periphery,vacuole173.017 -
N' NATIVEpr-GFP in SD
cytosol22.6253 -
N' TEF2pr-VC and Cyto-VN in SD
cell periphery39.3113 -
C’ GFP library in SD+DTT

cytosol26.721.11No -
C’ GFP library in SD+H2O2
cytosol16.370.68No -
C’ GFP library in Starvation Media
cytosol41.151.71No -
C’ GFP library on the background of Pup2-DaMP

cytosol -
C’ GFP library on the background of CCT mutant

cytosol22.12360.923372No
